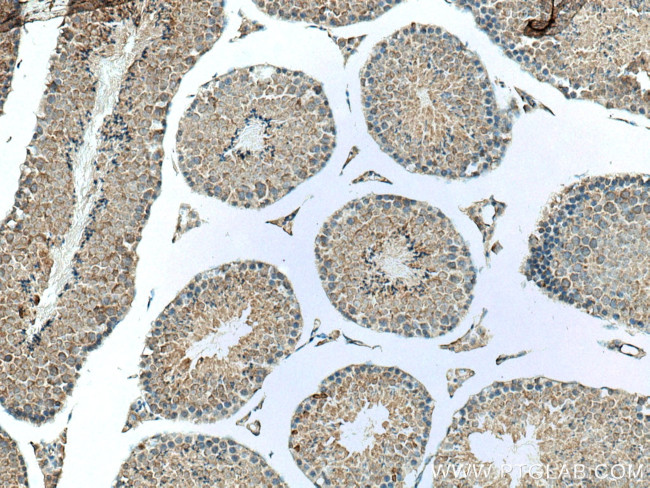
FAAH Antibody in Immunohistochemistry (Paraffin) (IHC (P))

Search
Proteintech
FAAH Polyclonal Antibody
{{$productOrderCtrl.translations['antibody.pdp.commerceCard.promotion.promotions']}}
{{$productOrderCtrl.translations['antibody.pdp.commerceCard.promotion.viewpromo']}}
{{$productOrderCtrl.translations['antibody.pdp.commerceCard.promotion.promocode']}}: {{promo.promoCode}} {{promo.promoTitle}} {{promo.promoDescription}}. {{$productOrderCtrl.translations['antibody.pdp.commerceCard.promotion.learnmore']}}










Please note: We are reviewing Western blot images included in the antibody testing data in our catalog, including those provided by third parties. Unless expressly labeled or annotated as “raw-unedited”, Western blot images included in the antibody testing data in our catalog may have been edited, optimized or otherwise adjusted for presentation.
产品信息
17909-1-AP
种属反应
已发表种属
宿主/亚型
分类
类型
抗原
偶联物
形式
浓度
规格
纯化类型
保存液
内含物
保存条件
运输条件
产品详细信息
Immunogen sequence: TDIGGSIRF PSSFCGICGL KPTGNRLSKS GLKGCVYGQE AVRLSVGPMA RDVESLALCL RALLCEDMFR LDPTVPPLPF REEVYTSSQP LRVGYYETDN YTMPSPAMRR AVLETKQSLE AAGHTLVPFL PSNIPHALET LSTGGLFSDG GHTFLQNFKG DFVDPCLGDL VSILKLPQWL KGLLAFLVKP LLPRLSAFLS NMKSRSAGKL WELQHEIEVY RKTVIAQWRA LDLDVVLTPM LAPALDLNAP GRATGAVSYT MLYNCLDFPA GVVPVTTVTA EDEAQMEHYR GYFGDIWDKM LQKGMKKSVG LPVAVQCVAL PWQEELCLRF MREVERLMTP EKQSS (236-579 aa encoded by BC093632)
靶标信息
Degrades bioactive fatty acid amides like oleamide, the endogenous levels of cannabinoid, anandamide and myristic amide to their corresponding acids, thereby serving to terminate the signaling functions of these molecules. Hydrolyzes polyunsaturated substrate anandamide preferentially as compared to monounsaturated substrates.
仅用于科研。不用于诊断过程。未经明确授权不得转售。
生物信息学
蛋白别名: amide hydrolase; Anandamide amidohydrolase 1; FA2H; FAAH-1; FAAH1; fatty acid amide hydrolase protein; Fatty acid ester hydrolase; Fatty-acid amide hydrolase 1; MGC102823; MGC138146; Oleamide hydrolase; Oleamide hydrolase 1; PSAB
基因别名: AW412498; FAAH; FAAH1
UniProt ID: (Mouse) O08914
Entrez Gene ID: (Rat) 29347, (Mouse) 14073